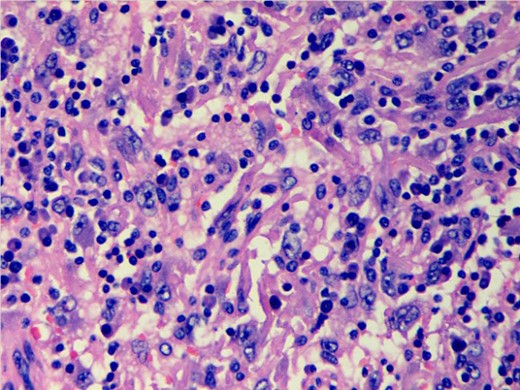
Photomicrograph showing scattered discohesive large cells with pleomorphic nuclei (H&E stain; ×400).

-
PDF
- Split View
-
Views
-
Cite
Cite
Jitendra Kumar Nangal, Akhil Kapoor, Satya Narayan, Mukesh Kumar Singhal, Surender Beniwal, Harvindra Singh Kumar, A case of CD68 negative histiocytic sarcoma of axilla masquerading as metastatic breast cancer, Journal of Surgical Case Reports, Volume 2014, Issue 7, July 2014, rju071, https://doi.org/10.1093/jscr/rju071
Close - Share Icon Share
Abstract
Histiocytic sarcoma is a malignant proliferation of cells showing morphological and immunophenotypic features of mature tissue histiocytes. Most of the cases in the literature have reported CD68 positivity. We report a case of histiocytic sarcoma whose presentation mimicked a metastatic breast cancer. A 40-year-female patient presented with a 13 × 11 cm left axillary mass in close proximity to the left breast. Tru-cut biopsy from the lesion suggested the diagnosis of a lymphoid neoplasm. Complete excision of the axillary mass was done. On simple microscopy, numerous mature small lymphocytes were seen dispersed in the follicles. Immunohistochemistry revealed CD31- and CD163-positive cells, which stained negative for CD68, CD1a, cytokeratin and S100; thus, confirming the diagnosis of histiocytic sarcoma.
INTRODUCTION
Histiocytic sarcoma (HS) is a rare aggressive malignant neoplasm of hematopoietic origin, representing <1% of all non-Hodgkin's lymphomas characterized by malignant proliferation of cells showing morphological and immunophenotypic features similar to those of mature tissue histiocytes [1]. Owing to the overlapping histological features and inadequate phenotypic data, malignancies have been misclassified as histiocytic tumors in the past. The awareness of features of HS is important, as the tumor closely mimics other lymphoid tissue malignancies in their clinical presentation and morphological appearance. We report a case of HS presenting as an isolated axillary mass in a 40-year-female patient which was previously investigated as a case of axillary metastasis arising from a hidden primary in the breast. To the best of our knowledge, no case of CD68 negative HS has been reported till date.
CASE REPORT
A 40-year-female patient presented with a large left axillary mass located in close proximity to the left breast (Fig. 1) which had gradually increased to its present size over a period of 3 months. There was no associated history of sweating or loss of weight. On examination, the mass was 13 × 11 cm in size at the level of anterior axillary nodes, firm in consistency with well-defined margins. No mass was palpable in either breast or any other lymph node in the entire body. The patient had undergone fine needle aspiration cytology at a peripheral hospital which revealed metastatic adenocarcinoma and, thus, was suspected to arise from a primary in the breast. However, diagnostic mammogram also failed to reveal any suspicious lesion in the breasts. Tru-cut biopsy of the lesion was performed, which revealed lymphocytes scattered throughout the tissue and no definite diagnosis was possible. Thus, excision biopsy of the mass was planned (Fig. 2). The cut surface of the surgical specimen was homogeneously brownish chocolate with central areas of hemorrhage. The section showed encapsulated mass covered by a thick fibrous capsule. The internal organization of the mass resembled a lymph node showing numerous follicles-like structures at the periphery. The center of the follicle was occupied by blood vessel; with swollen proliferating endothelial cells. The predominant cells in these follicles were mature small lymphocytes, large transformed cells and plasma cells (Fig. 3). At places, there were areas of hyalinization. Interfollicular areas showed numerous single and binucleated plasma cells intermingled with mature small lymphocytes, transformed lymphoid series cells, cells morphologically indistinguishable from Reed Sternberg cells, histiocytes and fibroblast. These histological features were suggestive of Castleman's disease showing patterns of both hyaline vascular type and plasma cell type (angiofollicular lymphoid hyperplasia). However, the second opinion of an experienced pathologist was taken who reported these findings to be suspicious of HS. To clear the diagnostic dilemma, immunohistochemistry (IHC) studies were done. All IHC markers were evaluated in the context of appropriate positive and negative controls. The tumor cells expressed CD31 and CD163 (Fig. 4) and were negative for S-100 protein, CD68, CD1a, CD23, CD21, cytokeratin, EMA, CD20, CD3, CD30, SMA, ERG, CD34 and CD35. Thus, the diagnosis of HS was clinched. Computed tomography scans of the thorax and the abdomen did not reveal any other site of lymphadenopathy. Bone marrow biopsy also failed to reveal any lymphoid infiltration. The patient is planned to receive six cycles of the standard Cyclophosphamide, Doxorubicin, Vincristine, Prednisolone chemotherapy.

Large mass in the left axillary region in proximity to breast.

Intra-operative picture showing encapsulated mass in the axilla.
Photomicrograph showing scattered discohesive large cells with pleomorphic nuclei (H&E stain; ×400).

Photomicrograph showing negative immunostaining with CD68 (A) and positive stain for CD163 (B).
DISCUSSION
HS remains to be a very rare and debatable diagnosis despite the introduction of term ‘HS’ as early as 1970 by Mathe et al. [2]. There have been no fixed diagnostic criteria for this entity and this led to several inconsistencies in the use of this terminology. Neoplasm originally classified as ‘reticulum cell sarcomas' and later ‘histiocytic lymphomas' by Rappaport [3] have encompassed a biologically heterogeneous group of disorders, the majority of which are now known to be high-grade T- or B-cell, non-Hodgkin lymphomas [4]. The malignant tumor in this case corresponded to the definition of HS according to the World Health Organization classification (WHO) [1], that is, a malignant proliferation of cells showing morphological and immunophenotypic features similar to those of mature tissue histiocytes. The 2001 WHO definition of HS required the absence of clonal B/T-cell receptor gene rearrangements. [1] However, the 2008 WHO classification no longer strictly requires the absence ofclonal immunoglobulin heavy chain (IgH) or T-cell receptor (TCR) gene rearrangement for the diagnosis of HS and suggests that rare cases with antigen receptor gene rearrangement are most likely examples of transdifferentiation [5].
HS is a hematopoietic neoplasm with aggressive behavior and poor outcome. It can present as localized disease confined to the skin, lymph nodes and intestinal tract, or as disseminated disease [6]. The median age of presentation is 46 years with slight male preponderance. Usually HS presents with systemic symptoms, including fever, weight loss and generalized weakness. However, in the present case, axilla involvement was isolated without any systemic features including the negative bone marrow study. Isolated involvement of the extradural thoracic spine by HS has been reported by Patnaik et al. [6].
Histological features consist of discohesive large cells with pleomorphic nuclei and abundant cytoplasm; however, a light microscopy alone is unreliable in establishing the diagnosis. Thus, immunophenotypic studies are essential to establish the diagnosis. Markers once regarded to be specific for histiocytic differentiation, such as α-1-antitrypsin, α-1-antichymotrypsin, lysozyme and CD68, have been shown to have low specificity as they can be positive in a wide variety of neoplasms [7]. Moreover, McHugh and Miettinen [8] reported both CD68 and α-1-antitrypsin immunoreactivity in melanoma with similar frequency to that of traditional melanoma markers (S-100, HMB-45), although the staining is usually not as intense. CD163 has recently been studied in a variety of benign and malignant tissues and shows almost exclusive expression in the cells of monocyte/macrophage lineage. In concordance with these studies, strong cytoplasmic immunoreactivity for CD163 was present in the case under discussion confirming histiocytic differentiation. Vos et al. [9] studied five cases of HS and concluded that CD163 appears to be a specific histiocytic marker and is important in establishing the diagnosis of HS. Most of the cases in the literature are reported to be a CD68 positive. However, in this patient, IHC markers were negative for myeloid cells (CD34), accessory/dendritic cell markers (CD1a, CD21 and CD35), CD30, S100; and metastatic carcinoma (epithelial membrane antigen). Thus, the diagnosis of HS was established.
Thus, to conclude, HS is a rare lesion and good histopathological study with IHC is required to clinch the diagnosis.
ACKNOWLEDGEMENTS
The authors convey sincere thanks to all the faculty members of department of oncology: Dr S.L. Jakhar, Dr R. Bothra, Dr N. Sharma, Dr A. Sharma and Dr M.R. Baradia for necessary support.
REFERENCES
Author notes
J.K.N. and A.K. contributed equally to the manuscript.